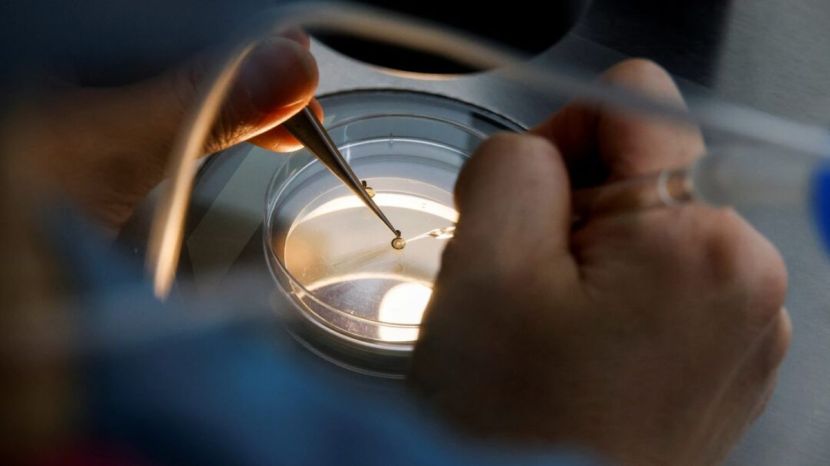

‘ह्युमन्स ऑफ बॉम्बे’च्या संस्थापक व सीईओ करिश्मा मेहता यांनी अलीकडेच खुलासा केला आहे की, त्यांनी वयाच्या ३२ व्या वर्षी त्यांची अंडी गोठवली. एका इन्स्टाग्राम पोस्टमध्ये त्यांनी सांगितले की, त्यांनी गेल्या महिन्यात त्यांची अंडी गोठवली होती. “बऱ्याच काळापासून हे करण्याचा विचार होता, अखेर ते पूर्ण झाले. मी महिन्याच्या सुरुवातीला माझी अंडी गोठवली,” असे त्यांनी स्पष्ट केले. निर्मात्या एकता कपूर आणि अभिनेत्री मोना सिंग यांसारख्या सेलिब्रिटींनी त्यांची अंडी गोठवल्याविषयी सांगितले होते. प्रियांका चोप्राने २०२३ मध्ये सांगितले होते की, त्यांनी वयाच्या ३० व्या वर्षी त्यांची अंडी गोठवली होती. देशातील शहरी भागातील तरुणींमध्ये अंडी गोठवण्याचे प्रमाण वाढत आहे. त्यामागील कारण काय? एग फ्रीजिंग म्हणजे नक्की काय? ते कितपत सुरक्षित आणि प्रभावी आहे? त्याचा खर्च किती येतो? त्याविषयी जाणून घेऊ.
एग फ्रीजिंग म्हणजे काय?
एग फ्रीजिंग किंवा oocyte cryopreservation या प्रक्रियेत स्त्रिया मातृत्वासाठी तयार होईपर्यंत त्यांची अंडी साठवून ठेवतात. या प्रक्रियेत साधारणतः आठ ते २० अंडी गोठवणे किंवा साठवणे समाविष्ट असते. जेव्हा एखादी स्त्री मूल व्हावे यासाठी तयार असते, तेव्हा साठवलेली अंडी तेव्हा साठवलेली अंडी गोठवलेल्या स्वरूपातून सामान्य स्वरूपात आणली जातात आणि मग इन विट्रो फर्टिलायझेशन (IVF) नावाच्या प्रक्रियेद्वारे प्रयोगशाळेत शुक्राणूंद्वारे फलित केली जातात. त्यानंतर त्या स्त्रीच्या गर्भाशयात त्या फलित अंड्याचे रोपण केले जातात.
फरीदाबाद येथील फोर्टिस एस्कॉर्ट्स हॉस्पिटलच्या प्रसूती व स्त्रीरोग विभागाच्या संचालक आणि प्रमुख डॉ. नीति कौतिश यांनी २०२४ मध्ये ‘इंडिया टुडे’ला सांगितले, “एग फ्रीजिंग ही एक वैद्यकीय प्रक्रिया आहे; ज्यामध्ये स्त्रीच्या शरीरातील अंडी काढली जातात आणि नंतर ती गोठवून पुढे साठवली जातात. स्त्रियांच्या पुनरुत्पादक वयात त्यांची प्रजनन क्षमता टिकवून ठेवण्याची पद्धत म्हणून ती ओळखली जाते.”
अंडी गोठवण्यामुळे स्त्रियांना त्यांच्या अंड्यांचा दर्जा नंतरच्या वापरासाठी टिकवून ठेवण्यास मदत होते. “या प्रक्रियेमध्ये अंडाशयांना उत्तेजित करण्यासाठी १० ते १२ दिवसांसाठी संप्रेरक इंजेक्शन्सचा समावेश केला जातो. त्यानंतर किरकोळ शस्त्रक्रियेद्वारे अंडी पुनर्प्राप्त केली जातात. नंतर अंडी विट्रिफिकेशन वापरून गोठवली जातात; ज्यामुळे त्यांची गुणवत्ता टिकून राहते. ही अंडी वर्षानुवर्षे साठवून ठेवली जाऊ शकतात आणि नंतर इन विट्रो फर्टिलायझेशन (IVF)साठी वापरली जाऊ शकतात,” असे बेबीसून फर्टिलिटी अॅण्ड आयव्हीएफ सेंटरच्या वैद्यकीय संचालक डॉ. ज्योती बाली यांनी ‘टाइम्स ऑफ इंडिया (TOI)’ला सांगितले.
एग फ्रीजिंगचे प्रमाण वाढण्याचे कारण काय?
असिस्टेड रिप्रॉडकटिव्ह टेक्नॉलजी (एआरटी)चा भाग असलेल्या अंडी गोठवण्याच्या प्रक्रियेची सुरुवात १९८० मध्ये कर्करोगासारख्या वैद्यकीय कारणांसाठी झाली. परंतु, आज तरुण स्त्रिया वैयक्तिक किंवा व्यावसायिक कारणांसाठी त्यांची प्रजनन क्षमता टिकवून ठेवण्याचा पर्याय म्हणून आपली अंडी गोठवत आहेत. अंडी गोठवल्याने त्यांना हवे तेव्हा मूल जन्माला घालण्याचा पर्याय मिळतो. कौटुंबिक किंवा सामाजिक दबावाखाली लग्न करून, मूल जन्माला घालण्याऐवजी त्यांना त्यांची आई होण्याची वेळ ठरवायची असते. ‘द हिंदू’शी बोलताना, भारतात पहिल्यांदा गोठलेल्या अंड्यांद्वारे बाळाला जन्म देणाऱ्या स्त्रीरोगतज्ज्ञ व क्लिनिकल भ्रूणशास्त्रज्ञ प्रिया सेल्वाराज म्हणाल्या की, ज्या स्त्रिया अंडी गोठवण्याचा पर्याय निवडतात, त्या शहरी भारतातील स्वतंत्र, खंबीर स्त्रिया आहेत.
“स्त्रियांना माहीत आहे की, शरीरात हळूहळू जैविक बदल होतो; परंतु किमान त्यामुळे त्यांची आई होण्याची आशा कायम राहते,” असे त्यांनी सांगितले. एखाद्या व्यक्तीच्या वयानुसार त्याची प्रजनन क्षमता कमी होत जाते, स्त्रियांमध्ये त्यांचे वय जसजसे वाढते, तसतशी प्रजनन क्षमता वेगाने कमी होते. त्यामुळे अंडी गोठवल्याने स्त्रियांना मातृत्व स्वीकारण्यासाठी अधिक वेळ मिळतो. स्त्रिया जन्माला येतात, तेव्हा त्यांच्या शरीरात मर्यादित संख्येने अंडी असतात, ज्यांचे प्रमाण आणि गुणवत्ता त्यांच्या ३० च्या उत्तरार्धात कमी होऊ लागते. पीसीओएस आणि एंडोमेट्रिओसिससारखी स्त्रीरोगविषयक परिस्थितीदेखील अंड्यांच्या गुणवत्तेवर परिणाम करू शकते. “भारतीय स्त्रिया ४६.२ वर्षांच्या सरासरी वयात रजोनिवृत्तीला पोहोचतात,” असे फोर्टिस फेमच्या वरिष्ठ संचालक व इंडियन मेनोपॉज सोसायटीच्या अध्यक्षा, स्त्रीरोगतज्ज्ञ मीनाक्षी आहुजा यांनी ‘द हिंदू’ला सांगितले.
त्या पुढे म्हणाल्या, “अनेक जण त्यांच्या वयाच्या ३० व्या वर्षी अंडी गोठवण्याचा विचार करू लागतात.” डॉ. ज्योती बाली यांनी गेल्या जूनमध्ये ‘TOI’शी संवाद साधला. त्या म्हणाल्या, “गेल्या पाच वर्षांत अंडी गोठवणाऱ्या महिलांमध्ये दरवर्षी २५ टक्के वाढ झाली आहे. हा पर्याय विशेषतः करिअर, पुढील शिक्षण किंवा योग्य जोडीदार शोधण्यावर लक्ष केंद्रित करण्यासाठी म्हणून निवडला जातो. उशीर झाला तरी मातृत्व अनुभवण्याची इच्छा असणाऱ्या स्त्रिया हा पर्याय निवडतात.”
ही प्रक्रिया किती महाग?
अंडी गोठवणे ही महागडी प्रक्रिया आहे; ज्यामुळे केवळ लोकांनाच ती परवडू शकते. ‘द हिंदू’नुसार, सुरुवातीच्या प्रक्रियेसाठी भारतात याच्या किमती १.५ लाख ते तीन लाख रुपयांपर्यंत आहेत. अंडी साठवण्यासाठी १०,००० ते ७५,००० रुपये वार्षिक शुल्कदेखील आकारले जाते. प्रजनन क्षमता संरक्षणासाठी विमा संरक्षणदेखील वेगळे आहे आणि सर्व योजनांमध्ये पूर्ण खर्च मिळविता येत नाही. परंतु, भारतात अजूनही याचा खर्च जागतिक दरांच्या तुलनेत परवडणारा आहे. ‘इंडियन एक्स्प्रेस’ने दिलेल्या वृत्तानुसार, अनेक महिला परदेशातून दक्षिण आशियाई देशात त्यांची अंडी गोठवण्यासाठी येत आहेत. वसंत विहारमधील अनंत फर्टिलिटी क्लिनिकच्या वैद्यकीय संचालक डॉ. निशा भटनागर यांनी गेल्या वर्षी वृत्तपत्राला सांगितले की, त्यांना ऑस्ट्रेलिया, कॅनडा, आफ्रिकन देश, नेपाळ व बांगलादेशमधील महिलांकडून याविषयी विचारणा केली जात आहे. “अनिवासी भारतीय (एनआरआय)देखील यात स्वारस्य दाखवत आहेत,” असे त्या म्हणाल्या.
अंडी गोठवणे सुरक्षित आणि प्रभावी आहे का?
अंडी गोठवण्याच्या प्रक्रियेचा स्त्रीचे मन आणि शरीर या दोहोंवर वास्तविक परिणाम होतो. ‘इंडिया टुडे’शी बोलताना, ब्लूम आयव्हीएफ इंडियाच्या संचालिका व आयव्हीएफ सोसायटी ऑफ इंडियाच्या अध्यक्षा डॉ. नंदिता पालशेतकर म्हणाल्या, “अंडी गोठवताना, स्त्रीला अंडाशयाच्या उत्तेजनासाठी हार्मोनल इंजेक्शन्स द्यावी लागतात. त्यामध्ये अल्ट्रासाऊंड आणि काही रक्त चाचण्यांद्वारे नियमित निरीक्षण केले जाते. या प्रक्रियेस सामान्यत: काही आठवडे लागतात आणि अनेक वेळा रुग्णालयांना भेटी द्याव्या लागू शकतात. या प्रक्रियेतून जात असलेल्या स्त्रियांमध्ये पोटात वायू धरणे / पोटफुगी आणि मळमळ होणे, ही लक्षणे सामान्य आहेत. तसेच या प्रक्रियेनंतर ओव्हरियन हायपर स्टिम्युलेशन सिंड्रोमचा धोकादेखील उद्भवू शकतो. ही अशी स्थिती असते, ज्यात अंडाशय फुगतात आणि काही काळासाठी वेदना होतात.
गुडगाव येथील क्लाउड नाईन हॉस्पिटलमधील वरिष्ठ सल्लागार व स्त्रीरोगशास्त्रज्ञ डॉ. रितू सेठी यांनी २०२३ मध्ये हिंदुस्तान टाइम्सला दिलेल्या मुलाखतीत सांगितले की, अंडी गोठवल्यानंतर अशक्तपणा किंवा थकवा जाणवणे हा सामान्य किंवा अपेक्षित परिणाम नाही. ही लक्षणे सामान्यत: कमकुवत रोगप्रतिकार शक्ती असलेल्या लोकांमध्ये दिसून येतात. सहायक पुनरुत्पादक तंत्रज्ञान (नियमन) कायदा, २०२१ नुसार भारतात १० वर्षांपर्यंत गोठवलेली अंडी साठवण्याची परवानगी आहे. पण, यात ही बाब लक्षात घेणे आवश्यक आहे की, अंडी गोठवणे म्हणजे बाळाची हमी नाही. कारण- याचा जन्मदर फार कमी आहे.
कोईम्बतूर येथील राव हॉस्पिटलचे सल्लागार, प्रजनन, एंडोस्कोपी व सहयोगी संचालक, दामोदर राव यांच्या मते, “महिलेचे वय यांसारख्या अनेक घटकांवर आधारित अंतिम जन्मदर १८ ते ५० टक्क्यांच्या दरम्यान असू शकतो. गोठवलेल्या अंड्यांची संख्या आणि भ्रूणशास्त्रज्ञाचे कौशल्य यांवर जन्मदर ठरतो,” असे ‘द हिंदू’च्या वृत्तात म्हटले आहे. तसेच, प्रत्येक स्त्री गोठवलेली अंडी वापरत नाही. अभ्यासातून असे दिसून आले आहे की, अंदाजे १२ ते २० टक्के स्त्रिया गर्भधारणेसाठी त्यांच्या गोठवलेली अंडी वापरतात. जर तुम्ही तुमची अंडी गोठवण्याचा विचार करत असाल, तर त्याबद्दल नीट विचार करणे आणि डुबकी घेण्यापूर्वी तुमच्या स्त्रीरोगतज्ज्ञांशी माहितीपूर्ण संभाषण करणे योग्य ठरेल.
